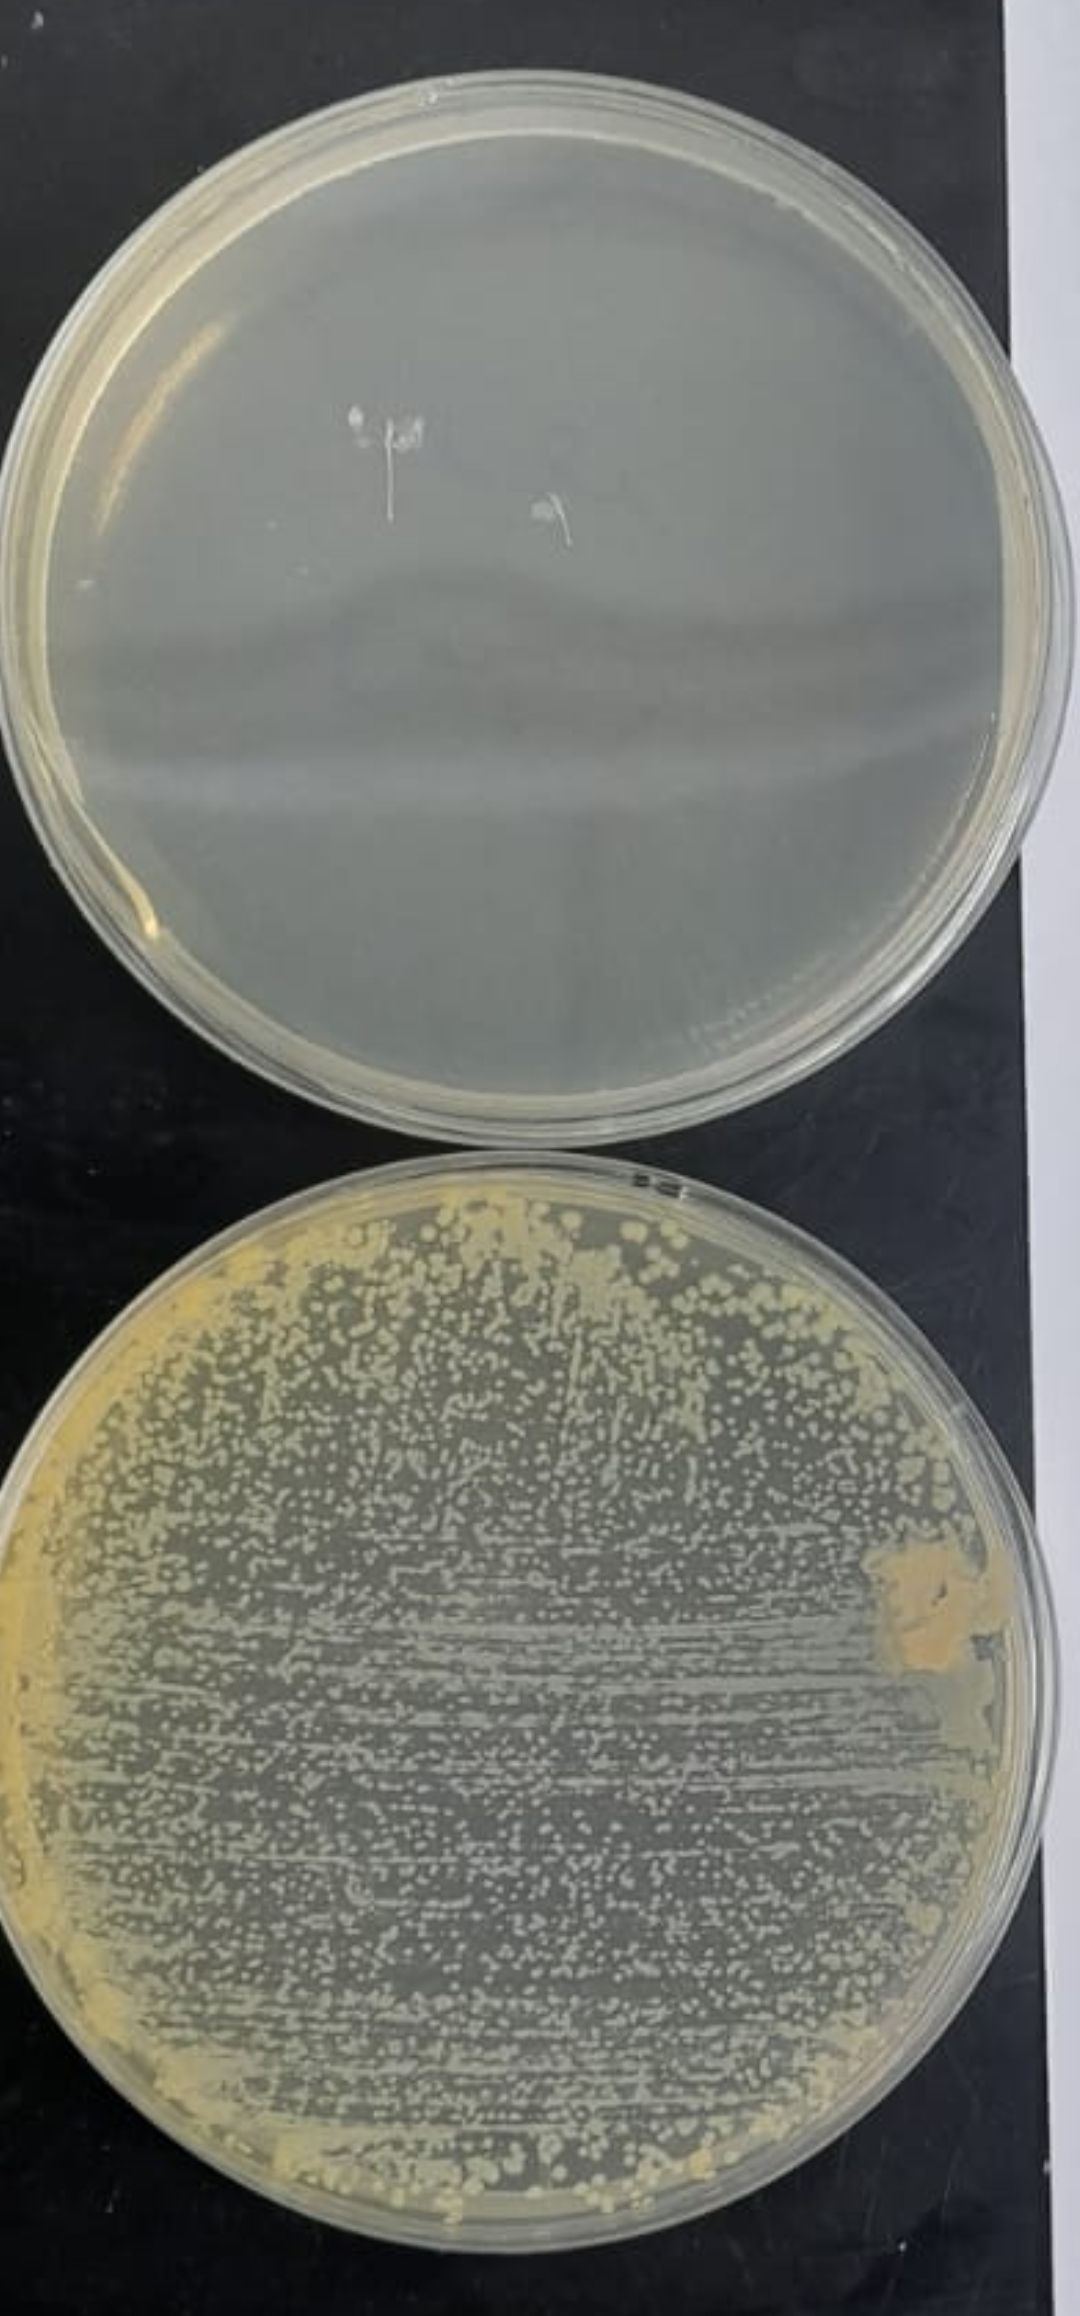

تخيل كائناً يبدو وكأنه خرج للتو من أفلام الخيال العلمي؛ سلطعون عملاق يكسر...
تعد الطبيعة مخزناً لا ينضب من العجائب، ومن بين أكثر كائناتها إثارة للدهشة...
أحد النسور الرائعة التي تنتشر في قارة اسيا، كما تنتشر ايضا في اجزاء...
الأرانب، هذه الكائنات الصغيرة اللطيفة، سنتحدث اليوم عنها وعن إناثها بصفة خاصة إنى...
اخواني أصحاب المشاريع زملائي الأطباء البيطريين تحية طيبة عملية اللقاح من اهم العمليات...
زملائي الأطباء البيطريين اخواني أصحاب المشاريع والمربين فيروسات آر إن إيه من أخطر...
زملائي الأطباء البيطريين اخواني أصحاب مشاريع البياض لتربية الدجاج البياض تحتاج اولا الى...
زملائي الأطباء البيطريين اخواني أصحاب المشاريع في الصورة يتضح الفرق لمسحة على وسط...
زملائي الأطباء البيطريين اخواني أصحاب المشاريع هنالك عدة علامات تدل على صحة ونشاط...
زملائي الأطباء البيطريين اخواني أصحاب المشاريع في الأيام الاولى من عمر الصيصان الكثير...